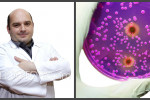

Դեպքեր
 Խոշոր հրդեհ Սոչիում. զոհվել է մեկ, տուժել 23 մարդ (video)
Խոշոր հրդեհ Սոչիում. զոհվել է մեկ, տուժել 23 մարդ (video)
 Տնօրենն այդ ձևով չպետք է ինքնապաշտպանվեր. Ա. Բախշյանը՝ դպրոցի սկանդալի մասին
Տնօրենն այդ ձևով չպետք է ինքնապաշտպանվեր. Ա. Բախշյանը՝ դպրոցի սկանդալի մասին
 Որ դեպքում են զինծառայողին արձակուրդ տրամադրելու
Որ դեպքում են զինծառայողին արձակուրդ տրամադրելու
 «Երկիր Ծիրանին» սկսում է համահայկական ընդվզումը
«Երկիր Ծիրանին» սկսում է համահայկական ընդվզումը
 Շղթայական ավտովթար Երևանում. կա վիրավոր
Շղթայական ավտովթար Երևանում. կա վիրավոր
 Հերթը հասավ Ջավադյանին
Հերթը հասավ Ջավադյանին
 Դատարանը մերժեց ՊՊԾ գնդի գրավման գործով մեղադրյալին ազատ արձակելու վերաբերյալ միջնորդությունը
Դատարանը մերժեց ՊՊԾ գնդի գրավման գործով մեղադրյալին ազատ արձակելու վերաբերյալ միջնորդությունը
 Դուք ստրուկ կամակատարներ եք. «Սասնա ծռեր-2»-ի գործով ամբաստանյալ Դեդը՝ դատավորին
Դուք ստրուկ կամակատարներ եք. «Սասնա ծռեր-2»-ի գործով ամբաստանյալ Դեդը՝ դատավորին
 Օրեր շարունակ մնացել է ծառերի ճյուղերի արանքում և մահացել
Օրեր շարունակ մնացել է ծառերի ճյուղերի արանքում և մահացել
 «Անլուրջ կլինի քննարկել ուռճացված, շոու դարձված որևէ խնդիր». Մարգարիտ Եսայանը՝ «Ծառուկյան» դաշինքին
«Անլուրջ կլինի քննարկել ուռճացված, շոու դարձված որևէ խնդիր». Մարգարիտ Եսայանը՝ «Ծառուկյան» դաշինքին
 «ԳԱԱ-ում ընդունելության համար նախատեսված 30 տեղերը թափուր են մնացել, ընդունվող չկա». Ռադիկ Մարտիրոսյան
«ԳԱԱ-ում ընդունելության համար նախատեսված 30 տեղերը թափուր են մնացել, ընդունվող չկա». Ռադիկ Մարտիրոսյան
 Նման բան գոյություն չունի այս օրենքով. Շարմազանով
Նման բան գոյություն չունի այս օրենքով. Շարմազանով
 Վարչապետի նոր բոցը Արցախում
Վարչապետի նոր բոցը Արցախում
 «Եվրոպայի սանկցիաները Ռուսաստանի նկատմամբ և դրա բումերանգի էֆեկտը».Ատոմ Մարգարյան (video)
«Եվրոպայի սանկցիաները Ռուսաստանի նկատմամբ և դրա բումերանգի էֆեկտը».Ատոմ Մարգարյան (video)
 «Բանակային խմորումներ և տարածաշրջանային զարգացումներ». Լարիսա Ալավերդյան (video)
«Բանակային խմորումներ և տարածաշրջանային զարգացումներ». Լարիսա Ալավերդյան (video)
 «ՀՀ-ում ակնաբույժին դիմողների թիվն աճել է». Լուսինե Բեկիրսկա-Թամազյան (ակնաբույժ) (video)
«ՀՀ-ում ակնաբույժին դիմողների թիվն աճել է». Լուսինե Բեկիրսկա-Թամազյան (ակնաբույժ) (video)
 «Ցավոք, կարճատեսության դեմ հնարավոր չէ պայքարել». Լուսինե Բեկիրսկա-Թամազյան (բժիշկ-ակնաբույժ) (video)
«Ցավոք, կարճատեսության դեմ հնարավոր չէ պայքարել». Լուսինե Բեկիրսկա-Թամազյան (բժիշկ-ակնաբույժ) (video)
 «Տղամարդիկ սովորաբար բացառում են սեռավարակակիր լինելը.սեռավարակների մասին մտածում են, երբ գանգատ ունեն». Հովհաննես Հովհաննիսյան (video)
«Տղամարդիկ սովորաբար բացառում են սեռավարակակիր լինելը.սեռավարակների մասին մտածում են, երբ գանգատ ունեն». Հովհաննես Հովհաննիսյան (video)
 «Ռուսաստանն Ադրբեջանին առանց Հայաստանի չափավոր չի կարող պահել». Լևոն Շիրինյան (video)
«Ռուսաստանն Ադրբեջանին առանց Հայաստանի չափավոր չի կարող պահել». Լևոն Շիրինյան (video)
 «Սաուդյան Արաբիա-Իրան հակամարտությունը հիշեցնում է Սովետական Միություն-ԱՄՆ առճակատումը».Արա Պապյան (video)
«Սաուդյան Արաբիա-Իրան հակամարտությունը հիշեցնում է Սովետական Միություն-ԱՄՆ առճակատումը».Արա Պապյան (video)
 «Մտահոգիչ է. Թուրքիան դեպի Ռուսաստան է գնում, մենք՝ դեպի Եվրոպա». Վազգեն Սաֆարյան (video)
«Մտահոգիչ է. Թուրքիան դեպի Ռուսաստան է գնում, մենք՝ դեպի Եվրոպա». Վազգեն Սաֆարյան (video)
 «Բոլորդ կարծում եք՝ իշխանավորնե՞րն են իրենց զավակներին ազատում բանակից. սխալվում եք». Լարիսա Ալավերդյան (video)
«Բոլորդ կարծում եք՝ իշխանավորնե՞րն են իրենց զավակներին ազատում բանակից. սխալվում եք». Լարիսա Ալավերդյան (video)
 «Դասախոսական կազմը ևս դեմ է տարկետման մասին օրենքի նախագծին». Լարիսա Ալավերդյան (video)
«Դասախոսական կազմը ևս դեմ է տարկետման մասին օրենքի նախագծին». Լարիսա Ալավերդյան (video)
 «Կարեն Կարապետյանը ՀՀԿ-ին կասկածելու տեղ ունի». Լարիսա Ալավերդյան (video)
«Կարեն Կարապետյանը ՀՀԿ-ին կասկածելու տեղ ունի». Լարիսա Ալավերդյան (video)
 «ԵՄ-ի հետ առաջիկա համաձայնագրում իշխանությունը փորձում է նոր բանաձև առաջ բերել». Վազգեն Սաֆարյան (video)
«ԵՄ-ի հետ առաջիկա համաձայնագրում իշխանությունը փորձում է նոր բանաձև առաջ բերել». Վազգեն Սաֆարյան (video)
 Գլենդելում Ռեյգանի դիմակով կողոպուտ իրականացրած հայեր են ձերբակալվել
Գլենդելում Ռեյգանի դիմակով կողոպուտ իրականացրած հայեր են ձերբակալվել
 «Սերժ Սարգսյանը, ժողովրդի լարերի վրա խաղալով, նախագահի աթոռի վրա գրում է վարչապետ». Լևոն Շիրինյան (video)
«Սերժ Սարգսյանը, ժողովրդի լարերի վրա խաղալով, նախագահի աթոռի վրա գրում է վարչապետ». Լևոն Շիրինյան (video)
 «Էս մարդը իր ողջ գործունեությունն անցկացրել է տարբեր պաշտոնյաների ընդունարաններում». Նիկոլ Փաշինյանը՝Վիգեն Սարգսյանին
«Էս մարդը իր ողջ գործունեությունն անցկացրել է տարբեր պաշտոնյաների ընդունարաններում». Նիկոլ Փաշինյանը՝Վիգեն Սարգսյանին
 «Պուտինյան Ռուսաստանն ընդունելի և անընդունելի բոլոր միջոցներով ձգտում է «ռուսական լուծում» տալ մխացող հակամարտությանը»
«Պուտինյան Ռուսաստանն ընդունելի և անընդունելի բոլոր միջոցներով ձգտում է «ռուսական լուծում» տալ մխացող հակամարտությանը»
 Վիեննայի և Սանկտ Պետերբուրգի համաձայնությունները կարծես թե նաև Մոսկվայի օրակարգում են
Վիեննայի և Սանկտ Պետերբուրգի համաձայնությունները կարծես թե նաև Մոսկվայի օրակարգում են
Լրահոս
 Ավտովթար է տեղի ունեցել Երևանում 21-ամյա վարորդի մասնակցությամբ
Ավտովթար է տեղի ունեցել Երևանում 21-ամյա վարորդի մասնակցությամբ
 Հաստատվեց. Ադրբեջանի փոխվարչապետի գլխավորած պատվիրակությունը Երևանում է
Հաստատվեց. Ադրբեջանի փոխվարչապետի գլխավորած պատվիրակությունը Երևանում է
 «Հրապարակ». Ժաննա Անդրեասյանը մեր երկիրը չի սիրում, նա մեր երկրի թշնամին է
«Հրապարակ». Ժաննա Անդրեասյանը մեր երկիրը չի սիրում, նա մեր երկրի թշնամին է
 «Հրապարակ»․ 2 տարի սահմանազատում չի արվում, Փաշինյանը խոսում է սահմանազատումից
«Հրապարակ»․ 2 տարի սահմանազատում չի արվում, Փաշինյանը խոսում է սահմանազատումից
 Ադրբեջանից պատվիրակություն է ժամանել Հայաստան
Ադրբեջանից պատվիրակություն է ժամանել Հայաստան
 Մահվան ելքով վրաերթ՝ Արագածոտնի մարզում. 47-ամյա տղամարդը մահացել է
Մահվան ելքով վրաերթ՝ Արագածոտնի մարզում. 47-ամյա տղամարդը մահացել է
 «Հրապարակ». Առաջին անգամ չեն խոսում Ջիլիզան հանձնելու մասին
«Հրապարակ». Առաջին անգամ չեն խոսում Ջիլիզան հանձնելու մասին
 Խայտառակություն․ իր ընկերոջ՝ Կանդազի հետ զրույցի համար արցախցուն տվել են տնային կալանք․ փաստաբան (video)
Խայտառակություն․ իր ընկերոջ՝ Կանդազի հետ զրույցի համար արցախցուն տվել են տնային կալանք․ փաստաբան (video)
 Ուժերը, որոնք չեն գիտակցում, որ դասական ընտրական պրոցեսներ չեն ընթանում, հաջողության հասնելու շանս չունեն
Ուժերը, որոնք չեն գիտակցում, որ դասական ընտրական պրոցեսներ չեն ընթանում, հաջողության հասնելու շանս չունեն
 «Փաշինյանը կամ պետք է պարտվի և պատասխանատվության ենթարկվի, կամ այնպես անի, որ ընտրություններն ազատ և արդար չլինեն»․ The Washington Times
«Փաշինյանը կամ պետք է պարտվի և պատասխանատվության ենթարկվի, կամ այնպես անի, որ ընտրություններն ազատ և արդար չլինեն»․ The Washington Times
 Անազնիվ պայքար
Անազնիվ պայքար
 Իրանի վեց խոշորագույն օդանավակայան վերսկսել է բնականոն գործունեությունը
Իրանի վեց խոշորագույն օդանավակայան վերսկսել է բնականոն գործունեությունը
 Մենք խիստ մտահոգված ենք Մերձավոր Արևելքում իրավիճակի զարգացմամբ. Նեբեզնյա
Մենք խիստ մտահոգված ենք Մերձավոր Արևելքում իրավիճակի զարգացմամբ. Նեբեզնյա
 «Թուրքի գործակալների մասին․․․․ ո՞վ են սրանք և ինչ են անում» (video)
«Թուրքի գործակալների մասին․․․․ ո՞վ են սրանք և ինչ են անում» (video)
 Ինչպես կմեկնարկեն քաղաքական թիմերը ԱԺ ընտրությունների քարոզարշավը. «Ժողովուրդ»
Ինչպես կմեկնարկեն քաղաքական թիմերը ԱԺ ընտրությունների քարոզարշավը. «Ժողովուրդ»
 ՔԿԾ-ն կալանավայրերի համար 27 մլն դրամով նոր տեսախցիկներ է գնել. Sputnik
ՔԿԾ-ն կալանավայրերի համար 27 մլն դրամով նոր տեսախցիկներ է գնել. Sputnik
 «Կապույտ անձնագրերը» ուժի մեջ են լինելու մինչև դրանց վավերականության ժամկետի ավարտը
«Կապույտ անձնագրերը» ուժի մեջ են լինելու մինչև դրանց վավերականության ժամկետի ավարտը
 Ադրբեջանցի վանդալները վնասել են օկուպացված Մարտունիի Սուրբ Ներսես Մեծ եկեղեցու գմբեթի խաչը
Ադրբեջանցի վանդալները վնասել են օկուպացված Մարտունիի Սուրբ Ներսես Մեծ եկեղեցու գմբեթի խաչը
 «Հրապարակ». Ժաննա Անդրեասյանը մեր երկիրը չի սիրում, նա մեր երկրի թշնամին է
«Հրապարակ». Ժաննա Անդրեասյանը մեր երկիրը չի սիրում, նա մեր երկրի թշնամին է
 Սամվել Կարապետյանի մասնակցությամբ այդ տեսանյութերը կազմված են պետական փաթեթով. Հակոբ Բադալյան
Սամվել Կարապետյանի մասնակցությամբ այդ տեսանյութերը կազմված են պետական փաթեթով. Հակոբ Բադալյան
 44-օրյա պատերազմում հերոսացած Ալբերտ Հովհաննիսյանի հայրը՝ Արտակ Հովհաննիսյանը, և մայոր Արթուր Ալավերդյանի հայրը՝ Արարատ Ալավերդյանը, փրկել են երիտասարդ տղայի կյանքը
44-օրյա պատերազմում հերոսացած Ալբերտ Հովհաննիսյանի հայրը՝ Արտակ Հովհաննիսյանը, և մայոր Արթուր Ալավերդյանի հայրը՝ Արարատ Ալավերդյանը, փրկել են երիտասարդ տղայի կյանքը
 Ընկերների միջև մի քանի ամսվա վաղեմության կենցաղային խոսակցությունը չի կարող կալանքի հիմք լինել. Վարդևանյան
Ընկերների միջև մի քանի ամսվա վաղեմության կենցաղային խոսակցությունը չի կարող կալանքի հիմք լինել. Վարդևանյան
 Լույս չի լինի
Լույս չի լինի
 Թրամփը պատրաստվում է Իրանի երկարատև շրջափակման
Թրամփը պատրաստվում է Իրանի երկարատև շրջափակման
 ՔՊ-ի շտաբներում մեծ թվով աշխատողներ են ընդունվել. «Հրապարակ»
ՔՊ-ի շտաբներում մեծ թվով աշխատողներ են ընդունվել. «Հրապարակ»
Ամենաընթերցվածները
 Ձեզ համար պարզ չէ՞՝ Աննա Հակոբյանն ու Փաշինյանն ինչ կրոն ունեն․ ռուս քաղաքագետ (video)
1
Ձեզ համար պարզ չէ՞՝ Աննա Հակոբյանն ու Փաշինյանն ինչ կրոն ունեն․ ռուս քաղաքագետ (video)
1
 Դուք լա՛վ լսեք՝ էդ ցուցակ են մտցնելու Փաշինյանին ու Աննա Հակոբյանին․ Կարապետ Պողոսյան (video)
2
Դուք լա՛վ լսեք՝ էդ ցուցակ են մտցնելու Փաշինյանին ու Աննա Հակոբյանին․ Կարապետ Պողոսյան (video)
2
 Նիկո՛լ, հլը ասա՝ էդ ո՞նց Կոշի գաղութից քեզ տեղափոխեցին Արթիկի գաղութ․ Սամվելյան (video)
3
Նիկո՛լ, հլը ասա՝ էդ ո՞նց Կոշի գաղութից քեզ տեղափոխեցին Արթիկի գաղութ․ Սամվելյան (video)
3
 «Թույլ չտա՛ք՝ տականքը մնա իշխանության»․ Նորատ Տեր-Գրիգորյանցի կոշտ խոսքը (video)
4
«Թույլ չտա՛ք՝ տականքը մնա իշխանության»․ Նորատ Տեր-Գրիգորյանցի կոշտ խոսքը (video)
4
«Նիկոլն Աննային բերման ենթարկեց, որ․․․»․ Հովհաննես Շահինյան (video)
5
«Նիկոլն Աննային բերման ենթարկեց, որ․․․»․ Հովհաննես Շահինյան (video)
5

Շուտով
Ապրիլի 29-ին՝ ժամը 12։00-ին, Հայելի ակումբի հյուրն է Ալբերտ Բազեյանը
Ապրիլի 29-ին՝ ժամը 16։30-ին, Հայելի ակումբի հյուրն է Նաիրա Գևորգյանը
Ապրիլի 29-ին՝ ժամը 15։30-ին, Հայելի ակումբի հյուրն է Արմենուհի Կյուրեղյանը
Ապրիլի 29-ին՝ ժամը 13։30-ին, Հայելի ակումբի հյուրն է Արմինե Ադիբեկյանը
Ապրիլի 29-ին՝ ժամը 12։30-ին, Հայելի ակումբի հյուրն է Կարինե Նալչաջյանը
Ապրիլի 28-ին՝ ժամը 16։00-ին, Հայելի ակումբի հյուրն է Վոլոդյա Հովհաննիսյանը
Ապրիլի 28-ին՝ ժամը 12։00-ին, Հայելի ակումբի հյուրն է Էդիկ Անդրեասյանը
Ապրիլի 28-ին՝ ժամը 13։30-ին, Հայելի ակումբի հյուրն է Հովհաննես Շահինյանը
Ապրիլի 28-ին՝ ժամը 15։30-ին, Հայելի ակումբի հյուրն է Կարապետ Պողոսյանը
Ապրիլի 28-ին՝ ժամը 15։00-ին, Հայելի ակումբի հյուրն է Աժ պատգամավոր Գառնիկ Դանիելյանը


